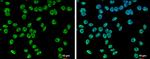
SETD1A Antibody in Immunocytochemistry (ICC/IF)

Search
Invitrogen
SETD1A Polyclonal Antibody
{{$productOrderCtrl.translations['antibody.pdp.commerceCard.promotion.promotions']}}
{{$productOrderCtrl.translations['antibody.pdp.commerceCard.promotion.viewpromo']}}
{{$productOrderCtrl.translations['antibody.pdp.commerceCard.promotion.promocode']}}: {{promo.promoCode}} {{promo.promoTitle}} {{promo.promoDescription}}. {{$productOrderCtrl.translations['antibody.pdp.commerceCard.promotion.learnmore']}}
图: 1 / 6
SETD1A Antibody (PA5-78298) in ICC/IF

产品信息
PA5-78298
种属反应
宿主/亚型
分类
类型
抗原
偶联物
形式
浓度
规格
纯化类型
保存液
内含物
保存条件
运输条件
RRID
产品详细信息
Predicted Reactivity: Bovine (90%)
Store product as a concentrated solution. Centrifuge briefly prior to opening the vial.
靶标信息
SET1A is a component of a histone methyltransferase (HMT) complex that produces mono-, di-, and trimethylated histone H3 at Lys4. The complex is the analog of the S. cerevisiae Set1/COMPASS complex.
仅用于科研。不用于诊断过程。未经明确授权不得转售。
篇参考文献 (0)
生物信息学
蛋白别名: Histone-lysine N-methyltransferase SETD1A; hSET1A; Lysine N-methyltransferase 2F; non-selective cation channel 1; SET domain-containing protein 1A; Set1/Ash2 histone methyltransferase complex subunit SET1
基因别名: BC010250; EPEDD; EPEO2; KIAA0339; KMT2F; mKIAA0339; mNSC1; NEDSID; Nsccn1; SET1; SET1A; SETD1A
UniProt ID: (Human) O15047, (Mouse) E9PYH6
Entrez Gene ID: (Human) 9739, (Mouse) 233904




